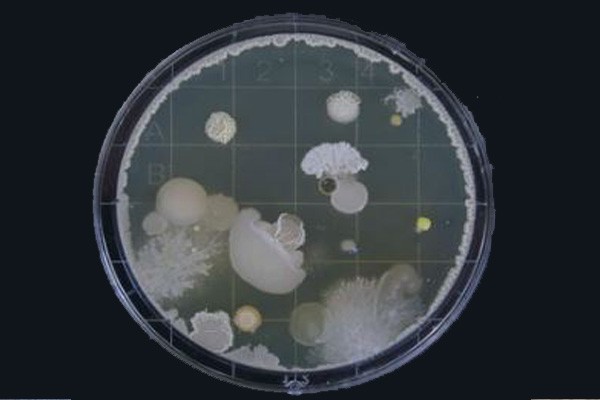
Mold Testing

Mold Testing
Whether you are worried about possible contaminates in your home’s air, looking to sample an unknown surface stain, or need clearance sampling to check a remediation performed by a third party we are equipped to help.
We can perform several different methods of sampling. Your inspector will explain to you the method of sampling best suited for your needs. We are equipped to perform Air Quality Sampling, Direct Swab Sampling, Bulk Sampling, or Tape Lift sampling. All sampling services include…
*Discreet handling of samples, including a chain of custody and sealed Fed Ex envelope for shipping.
*Lab analysis performed by a third-party lab. Lab results are released directly from the lab via PDF file. Once your results are complete you will receive a link to access the findings. We will call you to interpret the findings and discuss the next steps you will need to make. All samples are confidential and we will not share the results with anyone other than you.
*Written letter of clearance. If no elevated mold is found in your sample, you will receive a written letter of clearance for your records.
* If mold elevation is found a detailed mold remediation report will be provided to you outlining scope of work and cost.